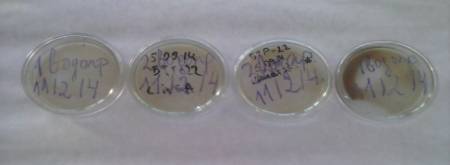
C:\Users\�����\Desktop\�������������\CAM02489.jpg
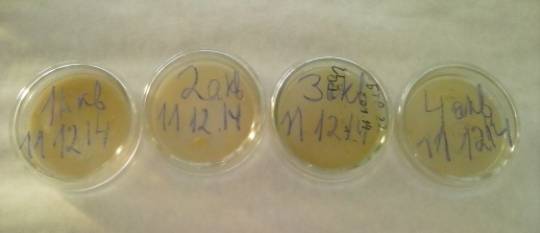
C:\Users\�����\Desktop\���������\���� ����\� ��������\CAM02478.jpg
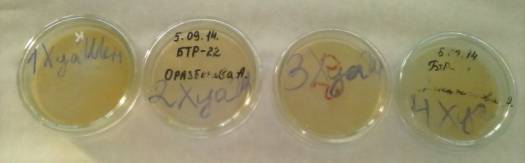
C:\Users\�����\Desktop\������\CAM02483.jpg

БИОЛОгические науки/ 6.Микробиология.
Магистр
естественных наук, Баймагамбетова А.Ш., магистр биологии Шакиржанова И.С.,
магистр естественных наук Маймакова Д.Б.
Кокшетауский государственный университет им.
Ш.Уалиханова, Казахстан.
Определения количества бактерий в пробах воды из разных источников города
Кокшетау.
Вода необходима для обеспечения
жизнедеятельности человека, обусловлена ролью, которую она играет в круговороте
природы, играет важную роль так и для растений. Так как она является
растворителем питательных веществ, которые вскоре разносятся по растению,
которые оказывают прямое воздействие на процессы происходящих в растениях.
Также важна в удовлетворении физиологических, гигиенических, рекреационных,
эстетических и других потребностей человека. Решение проблемы удовлетворения
потребностей человека в воде для различных целей тесно связано с обеспечением
ее необходимого качества. Судить о качестве воды и ее соответствии или
несоответствии установленным нормам можно только на основании максимально
полного химического и бактериологического анализа. Бактериологический
«коктейль» вместо чистой воды – одна из основных причин заболевания населением
кишечными и инфекционными заболеваниями человека. Серьезную опасность для
здоровья населения представляет микробиологическое загрязнение воды присутствием бактерий в ее содержании, что может
отрицательно оказать влияние на
здоровье человека, животных растений вызывая различные нарушения в органах и
тканях. Актуальна эта проблема и для нашего города.
По данным таблицы 1 в каждом разведении
водопроводной воды присутствуют бактерии. В 1:10 насчитывается 312 бактерий, в
1:100 разведении насчитывается 158 бактерий, в 1:1000 разведении насчитывается
80 бактерий, в 1:10000 разведении насчитывается 46 бактерий. По таблице 12
можно сделать вывод, что в каждом разведении количество бактерий присутствуют,
но и уменьшаются [1].
Таблица 12 Количественный учет бактерий в
водопроводной воде
|
Водопроводная
вода |
|
|
1:10 |
312 |
|
1:100 |
158 |
|
1:1000 |
80 |
|
1:10000 |
46 |
По рисунку
1 наблюдается, что в разведения водопроводной воды присутствуют
бактерии.
Рисунок
1 Посев водопроводной воды
По таблице 2
видно, что в каждом разведении
воды профильтрованной через Аквафор наблюдается сплошной рост бактерии.
Сплошной рост бактерии в разведениях говорит о том, что вода профильтрованная
через Аквафор имеет огромное число бактерии не уменьшающихся в разбавлениях.
Возможно, это связано с тем, что даннй фильтр использовался потребителем больше положенного срока эксплуатации.
Таблица
2 Количественный учет бактерий в воде
профильтрованной через Аквафор
|
Вода водопроводная
профильтрованная через Аквафор |
|
|
1:10 |
Сплошной рост |
|
1:100 |
Сплошной рост |
|
1:1000 |
Сплошной рост |
|
1:10000 |
Сплошной рост |
В рисунке 2 наблюдается сплошной рост бактерий
во всех разведениях воды профильтрованной через фильтр Аквафор.
Рисунок 2 Посев воды профильтрованной
через Аквафор
По таблице 3 видно, что также в кружке «ХуаШен» наблюдается сплошной рост
бактерий. Сплошной рост бактерий в разведениях говорит о том, что содержание
бактерий в разведениях не уменьшается, остается на постоянным уровне.
Таблица 3 Количественный учет бактерий в
воде выстоянной в кружке «ХуаШен» для структурирования воды
|
Вода бутилированная
выстоянная в кружке «ХуаШен» для структурирования воды |
|
|
1:10 |
Сплошной рост |
|
1:100 |
Сплошной рост |
|
1:1000 |
Сплошной рост |
|
1:10000 |
Сплошной рост |
Согласно рисунку 3 в разведениях наблюдается
сплошной рост бактерий посеянных в воде выстоянной в кружке «ХуаШен». Можно
сделать ввод, что кружка «Хуашен» не обладает антисептическими свойствами.
Рисунок 3 Посев воды выстоянной в
кружке «ХуаШен» для структурирования воды
Таблица 4 Количественный учет бактерий в
воде с источника улицы Чапаева микрорайона Жайляу
|
Вода с источника улицы
Чапаева (мкр. Жайлау) |
|
|
1:10 |
52 |
|
1:100 |
48 |
|
1:1000 |
30 |
|
1:10000 |
16 |
По данным рисунка 4 в каждом разведении воды с
источника ул. Чапаева присутствуют бактерии. В 1:10 насчитывается 52 бактерий,
в 1:100 разведении насчитывается 48 бактерий, в 1:1000 разведении насчитывается
30 бактерий, в 1:10000 разведении насчитывается 16 бактерий. По рисунку 22
можно сделать вывод, что в каждом разведении количество бактерий присутствуют,
но и уменьшаются.
Согласно рисунку 5 наблюдается незначительное
количество бактерий в каждом разведении. Но присутствие бактерий в воде с
источника ул. Чапаева (мкр. Жайляу ) наблюдается, однако, по сравнению с
другими тремя пробами вод в разведениях
из различных источников города Кокшетау данная вода является наиболее пригодна
для употребления по микробиологическому составу.

Рисунок
5 Посев воды с источника
улицы Чапаева мкр. Жайляу
В результате исследования было выявлено, что сплошной
рост бактерий был выявлен в водах: профильтрованной через фильтр Аквафор, воде выстоянной в кружке «ХуаШен», что
говорит о том, что данные проб вод наиболее микробиологически загрязнены. Незначительное
количество бактерий было обнаружено в водах с источника ул. Чапаева (мкр.
Жайляу), водопроводной воде.
Литература:
1
Мутанов Г. О реализации стратегии задачи повышения
качества образования в Казахстане. Алматы, «Высшая школа» № 1. 2003. С.31-39
2
Мягкова А.П., Комиссаров Б.Д. Методика
обучения общей биологии: Пособие для учителей. М.: Просвещение, 1985. С. 287
3
Настольная книга учителя биологии / Авт.-сост.
Г.С. Калинова, B.C. Кучменко. М.: ООО «Издательство ACT»:
«ООО Издательство Астрель», 2002.С. 158
4
Нугманов А. Информатизация образования //
Высшая школа Казахстана. -2002.-№1. С. 250
5
Пономарева И.Н., Соломин В.П. и др. Общая
методика обучения биологии: Учеб. пособие для студ. пед. вузов / Под
ред. И.Н. Пономаревой.-М.: Издательский центр «Академия», 2003. С. 272